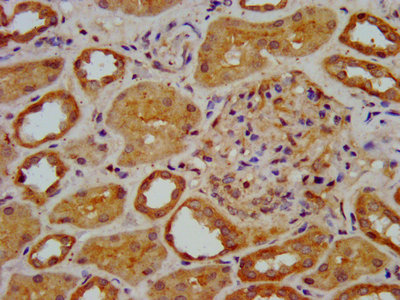

ELP3 Antibody
-
中文名稱:ELP3兔多克隆抗體
-
貨號:CSB-PA884499LA01HU
-
規格:¥440
-
圖片:
-
Western Blot
Positive WB detected in: Jurkat whole cell lysate, K562 whole cell lysate, 293 whole cell lysate
All lanes: ELP3 antibody at 3.82µg/ml
Secondary
Goat polyclonal to rabbit IgG at 1/50000 dilution
Predicted band size: 63, 61, 50, 53 kDa
Observed band size: 63 kDa -
IHC image of CSB-PA884499LA01HU diluted at 1:400 and staining in paraffin-embedded human kidney tissue performed on a Leica BondTM system. After dewaxing and hydration, antigen retrieval was mediated by high pressure in a citrate buffer (pH 6.0). Section was blocked with 10% normal goat serum 30min at RT. Then primary antibody (1% BSA) was incubated at 4°C overnight. The primary is detected by a biotinylated secondary antibody and visualized using an HRP conjugated SP system.
-
Immunofluorescence staining of Hela cells with CSB-PA884499LA01HU at 1:133, counter-stained with DAPI. The cells were fixed in 4% formaldehyde, permeabilized using 0.2% Triton X-100 and blocked in 10% normal Goat Serum. The cells were then incubated with the antibody overnight at 4°C. The secondary antibody was Alexa Fluor 488-congugated AffiniPure Goat Anti-Rabbit IgG(H+L).
-
Immunoprecipitating ELP3 in HEK293 whole cell lysate
Lane 1: Rabbit control IgG instead of CSB-PA884499LA01HU in HEK293 whole cell lysate. For western blotting, a HRP-conjugated Protein G antibody was used as the secondary antibody (1/2000)
Lane 2: CSB-PA884499LA01HU (6µg) + HEK293 whole cell lysate (500µg)
Lane 3: HEK293 whole cell lysate (20µg)
-
-
其他:
產品詳情
-
產品名稱:Rabbit anti-Homo sapiens (Human) ELP3 Polyclonal antibody
-
Uniprot No.:
-
基因名:ELP3
-
別名:DKFZp761L098 antibody; Elongation protein 3 homolog (S. cerevisiae) antibody; Elongation protein 3 homolog antibody; ELONGATION PROTEIN 3; S. CEREVISIAE; HOMOLOG OF antibody; elongator acetyltransferase complex subunit 3 antibody; Elongator complex protein 3 antibody; elp3 antibody; ELP3_HUMAN antibody; FLJ10422 antibody; hELP3 antibody; Hypothetical protein DKFZp761L098 antibody; Kat9 antibody
-
宿主:Rabbit
-
反應種屬:Human
-
免疫原:Recombinant Human Elongator complex protein 3 protein (1-85AA)
-
免疫原種屬:Homo sapiens (Human)
-
標記方式:Non-conjugated
本頁面中的產品,ELP3 Antibody (CSB-PA884499LA01HU),的標記方式是Non-conjugated。對于ELP3 Antibody,我們還提供其他標記。見下表:
-
克隆類型:Polyclonal
-
抗體亞型:IgG
-
純化方式:>95%, Protein G purified
-
濃度:It differs from different batches. Please contact us to confirm it.
-
保存緩沖液:Preservative: 0.03% Proclin 300
Constituents: 50% Glycerol, 0.01M PBS, pH 7.4 -
產品提供形式:Liquid
-
應用范圍:ELISA, WB, IHC, IF, IP
-
推薦稀釋比:
Application Recommended Dilution WB 1:500-1:5000 IHC 1:200-1:500 IF 1:50-1:200 IP 1:200-1:2000 -
Protocols:
-
儲存條件:Upon receipt, store at -20°C or -80°C. Avoid repeated freeze.
-
貨期:Basically, we can dispatch the products out in 1-3 working days after receiving your orders. Delivery time maybe differs from different purchasing way or location, please kindly consult your local distributors for specific delivery time.
-
用途:For Research Use Only. Not for use in diagnostic or therapeutic procedures.
相關產品
靶點詳情
-
功能:Catalytic tRNA acetyltransferase subunit of the RNA polymerase II elongator complex, which is a component of the RNA polymerase II (Pol II) holoenzyme and is involved in transcriptional elongation. The elongator complex is required for multiple tRNA modifications, including mcm5U (5-methoxycarbonylmethyl uridine), mcm5s2U (5-methoxycarbonylmethyl-2-thiouridine), and ncm5U (5-carbamoylmethyl uridine). In the elongator complex, acts as a tRNA uridine(34) acetyltransferase by mediating formation of carboxymethyluridine in the wobble base at position 34 in tRNAs. May also act as a protein lysine acetyltransferase by mediating acetylation of target proteins; such activity is however unclear in vivo and recent evidences suggest that ELP3 primarily acts as a tRNA acetyltransferase. Involved in neurogenesis: regulates the migration and branching of projection neurons in the developing cerebral cortex, through a process depending on alpha-tubulin acetylation. Required for acetylation of GJA1 in the developing cerebral cortex.
-
基因功能參考文獻:
- and CTU1/2, partner enzymes in U34 methoxycarbonylmethyl-2-thio tRNA modification, are up-regulated in human breast cancers and sustain metastasis. PMID: 27811057
- Promoter hypermethylation is an important mechanism of the transcriptional inactivation of ELP3 in invasive ductal breast carcinoma. PMID: 25148870
- Regulation of G6PD acetylation by SIRT2 and KAT9 modulates NADPH homeostasis and cell survival during oxidative stress. PMID: 24769394
- data suggest that hElp3 can regulate the transcription of HSP70 gene, and the HAT domain of hElp3 is essential for this function PMID: 22216241
- The results of this study uncover a novel role for Elp3 in the regulation of synaptic bouton expansion during neurogenesis that may be linked with a requirement for sleep. PMID: 20626565
- Elp3 promotes the acetylation of alpha-tubulin in microtubules in neurological disorders. PMID: 20036197
- We used hELP3 antisense oligonucl. to knock down hELP3 gene. The results showed that reduction of hELP3 mRNA and protein caused a suppression of HSP70-2 and histone H3 hypoacetylation. PMID: 17558451
- Allelic variants of ELP3 were associated with amyotrophic lateral sclerosis in three populations comprising 1483 people. PMID: 18996918
- ELP3 localises to mitochondria in HeLa cells, actin-like filaments, and actin-rich sites at the edges of spreading cells. This suggests that ELP3 and the ELONGATOR complex may play a role in mitochondrial function, actin organisation, and cell motility. PMID: 19429107
顯示更多
收起更多
-
相關疾病:ELP3 genetic variations may be associated with an increased risk for neurodegeneration and motor neuron diseases.
-
亞細胞定位:Cytoplasm. Nucleus.; [Isoform 1]: Nucleus.; [Isoform 2]: Cytoplasm. Nucleus.
-
蛋白家族:ELP3 family
-
組織特異性:Expressed in the cerebellum and spinal motor neurons.
-
數據庫鏈接:
Most popular with customers
-
-
YWHAB Recombinant Monoclonal Antibody
Applications: ELISA, WB, IHC, IF, FC
Species Reactivity: Human, Mouse, Rat
-
Phospho-YAP1 (S127) Recombinant Monoclonal Antibody
Applications: ELISA, WB, IHC
Species Reactivity: Human
-
-
-
-
-